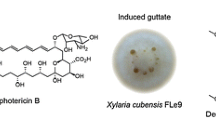

Abstract
Diosgenin is widely used as one precursor of steroidal drugs in pharmaceutical industry. Currently, there is no choice but to traditionally extract diosgenin from Dioscorea zingiberensis C. H. Wright (DZW) or other plants. In this work, an environmentally friendly approach, in which diosgenin can be bio-synthesized by the endophytic bacterium Bacillus licheniformis Syt1 isolated from DZW, is proposed. Diosgenin produced by the strain was identified by high-performance liquid chromatography (HPLC), nuclear magnetic resonance (NMR), and Fourier transform infrared spectroscopy (FTIR). The thermal gravimetric analysis (TGA) showed that the melting point of the diosgenin product was 204 °C. The optical rotation measurement exhibited that the optical rotation was α20589 = − 126.1° ± 1.5° (chloroform, c = 1%): negative sign means that the product is left-handed, which is very important to further produce steroid hormone drugs. Cholesterol may be the intermediate product in the diosgenin biosynthesis pathway. In the batch fermentation process to produce diosgenin using the strain, pH values played an important role. A phased pH control strategy from 5.5 to 7.5 was proved to be more effective to improve production yield than any single pH control, which could get the highest diosgenin yield of 85 ± 8.6 mg L−1. The proposed method may replace phyto-chemistry extraction to produce diosgenin in the industry in the future.
Key points
• An endophytic Bacillus licheniformis Syt1 derived from host can produce diosgenin.
• A dynamic pH industrial control strategy is better than any single pH control.
• Proposed diosgenin-produced method hopefully replaces phyto-chemistry extraction.
Similar content being viewed by others
Avoid common mistakes on your manuscript.
Introduction
Diosgenin (CAS number 512–04-9) is widely used to synthesize oral contraceptives, sex hormones, and other steroid drugs in pharmaceutical industry (Chen et al. 2015; Lepage et al. 2010). Consequently, the demands are gradually increasing in the world market; most commercial supply of diosgenin in global market is from China and North America, where diosgenin are mainly extracted from Dioscorea plants (Bai et al. 2015; Dawson 1991; Fernandes et al. 2003; Pan et al. 2014). Dioscorea zingiberensis C. H. Wright (DZW) is one major plant in Dioscorea genus, which is also traditionally called yellow ginger, and dominantly used to extract diosgenin in China (Wang et al. 2014; Zhang et al. 2012). As a result, the production of diosgenin always consumes a large number of DZW, which consequently results in overly depending on DZW resources. The status has brought about two negative social issues. Firstly, the endless excavation of DZW consequently causes a serious damage to the ecological environment and the degradation of DZW germplasm. Secondly, it often generates a lot of wastewater and acids in the phyto-chemistry extraction process of diosgenin from DZW (Pan et al. 2014; Wei et al. 2013; Yang et al. 2016). Some factories have been banned from extracting diosgenin from DZW by government for the reasons in China. Therefore, there is an urgent need to find a green, easily industrialized way to produce diosgenin.
Although several improving approaches had been reported, in which diosgenin was obtained by enzymatically hydrolyzing saponins, these methods all relied on the hydrolase system of some fungi such as Trichoderma harzianum or Trichodermareesei, Aspergillus fumigatus, or Aspergillus awamori (Chen et al. 2018; Cheng et al. 2015; Liu et al. 2010; Zhu et al. 2010). But these methods had a premise that saponins were also extracted and purified from Dioscorea plants in advance, which did not solve the abovementioned problems of phyto-chemistry extraction. Moreover, most of the previous studies were limited to the Erlenmeyer flask scale rather than the batch fermentation scale.
The aims of this work were to isolate and identify an endophytic bacterium Bacillus licheniformis Syt1 derived from DZW which can produce diosgenin without DZW. Moreover, an optimized pH control strategy to maximize production rate was screened in batch fermentation process. The proposed method depending on microgram fermentation to produce diosgenin would be further easy to be industrialized in factory without DZW cultivation in an environmentally friendly way, which is promising to replace the traditional phytochemical extraction from DZW.
Materials and methods
Materials and chemicals
Tubers of DZW were obtained from National Engineering Research Center for Phytochemistry (West). Pure water was produced by a UPHW-I-90Z model ultra-pure water instrument (Shanghai Youpu industrial Co. Ltd, Shanghai, China). Analytical grade alcohol was purchased from Nanjing Chemical Reagent Co., Ltd. Analytical grade mercury dichloride (HgCl2), sodium chloride, sodium hydroxide and calcium chloride, and sucrose were all purchased from Tianjin Bodi Chemical Co., Ltd. Potato dextrose agar medium (PDA) was supported by Beijing Aobox Biotechnology. 120# gasoline was pursed from Shenzhen HCH Chemical Co., Ltd. Analytically pure petroleum ether, ethyl acetate, and chloroform reagents were bought from Sigma-Aldrich China. The powder of soybean cake was purchased from Tianjin Lifalong Chemical Technology Co., Ltd. HPLC-grade standard product of diosgenin (purity ≥ 98%) and methanol (MeOH) were purchased from Dalian melone Biotechnology Co., Ltd. DNA extraction kit and other genetic engineering reagents were from Takara China. The used primers were synthesized by Sangon Biotech of Shanghai, China.
Endophytic strains screening and target product analysis
The strong tubers of DZW were cleaned with sterile pure water and cut into 5 cm × 5 cm pieces, and soaked in 75% (v/v) alcohol solution for 30 s. Subsequently, they were immersed into a 0.1% HgCl2 solution for 5 min, and then rinsed 3 times with sterile water, and kept their surface sterile through plate culture verification. Continuously, these sterile 5 cm × 5 cm pieces were further cut into 5 mm × 5 mm pieces under sterile conditions. Every two pieces of them were incubated on a PDA plate at 28 °C for 3 ~ 5 days until endophytic microorganisms in tubers grew up. The obtained endophytic microorganism strains were isolated and purified on new PDA plates, then, were separately checked whether they could produce diosgenin in the following fermentation process. Every endophytic strain was individually cultured in an optimal medium consisted of 30 g/L sucrose, 6 g/L NaCl, 15 g/L CaCl2, and 15 g/L soybean powder, and pH was at 7.0. The whole fermentation process was maintained at 28 °C with 120r/min for 100 h under aerobic culture condition. The cultured cells were harvested by centrifugation at 5000 rpm and all cell pellets were hydrolyzed with 2 mol L−1 hydrochloric acid at 90 °C for 4 h. The hydrolytic liquid was cooled to room temperature and neutralized to pH 7.0 with 1 mol L−1 sodium hydroxide, and then extracted with 120# gasoline for 4 h in reflux way in a Soxhlet extractor, the gasoline phase was isolated within a separating funnel after static layering. The gasoline in gasoline phase was completely evaporated to obtain the crude extract. The crude extract was subjected to 200 mesh silica gel column chromatography (Φ30 × 300 mm) purification. In detail, the loading height of the adsorbent filler in column was 200 mm, and target diosgenin was eluted by a cosolvent (petroleum ether:ethyl acetate = 2:1, v/v). The eluate was collected, concentrated at 80 °C, and crystallized at 4 °C to obtain diosgenin-like crystal. 0.2600 g diosgenin-like crystal was accurately weighed for and dissolved in 1L methanol (0.26 mg/mL), which was analyzed by high-performance liquid chromatography analyzer (Waters 2996 diode-array detector) equipped with a Symmetry® C18 column (4.6 × 250, 5 μm). The mobile phase was MeOH/H2O (v/v = 95/5) and the flow rate was 0.6 mL/min, and column temperature was controlled at 25 °C. Injection volume of sample was 10 μL. Detection wavelength was set at 280 nm. 0.1 mg/mL diosgenin standard solution was used as control. Each experiment was performed in triplicate under the same condition.
Physical properties identification of diosgenin-like crystal product
The melting point of the obtained diosgenin-like crystal product was determined by the Shimadzu DTG-60 (Shimadzu, Shanghai, China) using thermal gravimetric analysis (TGA) method according to the previous report (Macêdo et al. 1999). In advance, the diosgenin-like crystal product was dried for 72 h in a desiccator at an ambient temperature in advance. Then, 0.900 g dried crystal product was loaded into DTG-60 and heated with a rise rate of 10 °C min−1; a nitrogen atmosphere was used, at a flow rate of 50 mL/min. The thermal gravimetric (TG) curve was analyzed with the aid of software of the instrument. The melting point was determined according to reduction in mass.
Comparisons of the Fourier transform infrared (FT-IR) spectrum of the obtained diosgenin-like crystal product with diosgenin standard product were screened by a Bruker vertex70 infrared spectrometer system (Bruker China Co., Ltd., China) according to the previous report (Zhang et al. 2009). The crystal product and standard product were both dried 2 days ago prior to FT-IR measurement. Round transparent tablet contained the crystal product sample or diosgenin standard product was subjected to 32 scans with 4 cm−1 resolution in the region of 4000–500 cm−1 by the Bruker vertex 70 infrared spectrometer, respectively.
NMR spectra of the obtained diosgenin-like crystal product and diosgenin standard (control group) were analyzed by 500 MHz spectrometer for 1H NMR and 126 MHz for 13C NMR (Bruker, Billerica, MA, USA) according to the report (Mamay, Wahyuningrum and Hertadi 2015) with little modifications. The diosgenin-like crystal product or diosgenin standard was solved in CDCl3 in the process, respectively.
The optical rotation of the obtained diosgenin-like crystal product was determined using a WZZ-2S digital automatic polarimeter (Shanghai, China) according to papers (Duan et al. 2018; Eibler and Vetter 2017). One percent (w/v) diosgenin-like crystal product in chloroform was prepared and determined at 589 nm under 20 °C, while pure chloroform served as blank control.
The species identification of the target strain
The strain to produce diosgenin was identified by 16S rDNA sequence with polymerase chain reaction (PCR). The genomic DNA of the strain was isolated with Takara MiniBEST Agarose Gel DNA Extraction Kit according to the instruction, which was used as the PCR amplification template; the used forward (Fw) primer was 5′-AGAGTTTGATCCTGGCTCAGAACG-3′, and the reverse (Rv) primer was 5′-TACGGCTACCTTGTTACGACTTCAC-3′. Twenty-five microliters of the PCR reactant was mixed well with 1 μL 10 μmol/L Fw primer, 1 μL 10 μmol/L Rv primer, 2.5 μL 10 × PCR buffer, 1 μL 2.5 mM dNTP mixture, 1.0 μL DNA template, 0.4 μL rTaq enzyme, and 18.1 μL nuclease-free water. PCR was carried out in the Bio-rad® ALD1244 DNA Engine (Bio-Rad, USA). The adopted PCR protocol was as follows: (1) initial denaturation temperature was 94 °C for 3 min; (2) 30 cycles, every cycle including 94 °C for 30 s, 58 °C for 30 s, and 72 °C for 1 min; (3) final extension step was maintained at 72 °C for 5 min. The PCR product was sequenced by Shanghai Sangon Biotech of China after our purification. The obtained 16S sequence was compared with NCBI data to determine species. The phylogenetic tree was constructed by neighbor joining method using by MEGA software version 7.0 (Kumar et al. 2016; Pidiyar et al. 2003). The colony morphology and structure of the target strain was analyzed using transmission electron microscope (TEM) and atomic force microscopy (AFM) (Bruker Company, USA).
Effect of pH on diosgenin yield and pH optimization in batch fermentation
At the optimal growth temperature of this strain, pH values may play an important role to produce diogenin in batch fermentation. Therefore, pH optimization was made to improve the diosgenin yield. Different pH tests were carried out in a fermentation medium with the same composition as the abovementioned in a 5-L automatically controlled BioFlo batch Fermenter (No.500998196, New Brunswick Scientific Co., Inc., USA). pH value of medium was in turn set at 5.5, 6.0, 6.5, 7.0, 7.5, and 8.0 in the batch fermentation; the pH during cultivation was detected by a pH electrode attached to a PID controller equipped to the fermenter, and the adjusting and stabilizing of pH values were automatically performed by adding 0.1 N hydrochloric acid or sodium hydroxide with two trickle feed pumps controlled by a computer program. The inoculation amount was 10%. The other conditions of all fermentation trials were maintained at 28 °C with 200 rpm stirring for 80 h, while 1.0 L−1 min−1 ventilation was given into the fermenter, 0.2% poly-siloxane was used as defoamer. Sampling was performed every 4-h interval, and the yields of diosgenin were analyzed using multi-well microplate spectrophotometry according to the previous paper (Li et al. 2012). Production rates of diosgenin were calculated by the following formula.
where Y is the production rates of diosgenin, mg L−1 h−1; Δt is the fermentation time increment, h; ΔC is the concentration variation of diosgenin in Δt period, mg L−1. Each experiment was repeated for three times. In order to maximize production rate of diosgenin, a phased pH control strategy was practiced in the fermenter according to the above effects of pH on production rates.
Statistical analysis
The results of all were analyzed by statistical software SPSS 18.0.
Results
Identification of diosgenin-like crystal product
A total of three endogenous strains were obtained. Only one strain was found to produce the diosgenin-like crystal product. The diosgenin-like crystal product was identified by HPLC. Its retention time was at 4.100 min in HPLC chromatogram as Fig. 1A showed, which coincided with that of diosgenin standard. It was preliminarily inferred that the diosgenin-like crystal product is most likely diosgenin. The purity of the diosgenin product was calculated by peak area ratio method to be ~ 96.20%. The melting point curve of the diosgenin-like crystal product was further determined by the thermal gravimetric analysis method (TGA). It can be seen that it began melting at 204 °C from the obtained melting point curve as Fig. 1B showed, which is consistent with previous reports (Zhang et al. 2009, 2007).
The identification of the diosgenin-like crystal product. A Chromatograms of the diosgenin-like crystal product and diosgenin standard. Therein, peak 1: the chromatogram of the diosgenin-like crystal product; peak2: the chromatogram of diosgenin standard product. B The thermal gravimetric analysis curve of the diosgenin-like crystal product. C FT-IR spectra of the diosgenin-like crystal product (in black) and diosgenin standard (in red). D The molecular structure formula of diosgenin. E 1H NMR of the diosgenin-like crystal product (in blue) and diosgenin standard (in red). F 13C NMR of the diosgenin-like crystal product (in blue) and diosgenin standard (in red)
The FT-IR spectrum of the diosgenin-like crystal product was displayed in Fig. 1C. It can be seen that the spectrum shape of the crystalline product is almost the same with that of diosgenin standard except difference in transmitted light intensity, especially same in the range between 1800 and 600 cm−1, where it is the major fingerprint area of diosgenin. In other areas with typical characteristics, a large OH-stretching vibration is at 3525 cm−1, which is consistent with –OH in diosgenin molecular structure as Fig. 1D showed. Four strong absorption peaks between 2950 and 2834 cm−1 wavenumber values are presumed to be asymmetric stretching vibrations of four methyl groups (–CH3) as showed in Fig. 1D. A stretch absorption peak of a –C = C– group appears at 1680 cm−1, indicating one –C = C– group in diosgenin molecular structure as in Fig. 1D. About six strong absorption bands between 1458 and 1130 cm−1 are inferred to be deformation vibrations of four six-membered rings and two five-membered rings in diosgenin molecular structure. Strong absorptions between 1050 and 980 cm−1 should be due to –C–O–C– stretches in diosgenin molecule according to previous reports (Cavagna et al. 2010; Gong et al. 2019; Kos et al. 2003). A number of characteristic absorption bands in the range 980–500 cm−1 should be out-of-plane bending vibrations of C-H bonds in the spiral skeleton of diosgenin molecule. In addition, the optical rotation of the crystal-like product was further determined to be \({\alpha }_{589}^{20}=-126.1^\circ \pm 1.5^\circ\) (chloroform, c = 1%), which was similar with that of standard. A negative sign means the product is left-handed, which is very important for producing steroid hormone drugs using diosgenin, because left-handed stereoselectivity is closely related to drug activity (Davies 1990). NMR spectrum of the diosgenin-like crystal product and standard was recorded using 500-MHz spectrometer for 1H NMR and 126 MHz for 13C NMR. The 1H NMR spectrum data (500 MHz, CDCl3) of the diosgenin-like crystal product are as follows: δ 5.37 − 5.32 (m, 1H), 4.40 (q, J = 7.5 Hz, 1H), 3.49 (ddq, J = 25.7, 10.9, 3.4, 2.3 Hz, 2H), 3.37 (t, J = 10.9 Hz, 1H), 2.33–2.27 (m, 1H), 2.23 (ddd, J = 13.2, 10.8, 2.8 Hz, 1H), 2.05–1.93 (m, 2H), 1.85 (ddt, J = 14.2, 10.6, 5.6 Hz, 3H), 1.81–1.70 (m, 2H), 1.70–1.51 (m, 9H), 1.51–1.39 (m, 3H), 1.28 (dq, J = 19.8, 6.7 Hz, 1H), 1.23–1.04 (m, 3H), 1.02 (s, 3H), 0.97 (d, J = 7.0 Hz, 4H), 0.78 (t, J = 3.2 Hz, 6H). The 13C NMR spectrum data (126 MHz, CDCl3) of the diosgenin-like crystal product are as follows: δ 140.8(C-1), 121.5(C-2), 109.3(C-3), 80.9(C-4), 71.8(C-5), 66.9(C-6), 62.1(C-7), 56.5(C-8), 50.1(C-9), 42.3(C-10), 41.6(C-11), 40.3(C-12), 39.8(C-13), 37.2(C-14), 36.7(C-15), 32.1(C-16), 31.9(C-17), 31.6(C-18), 31.5(C-19), 31.4(C-20), 30.3(C-21), 28.9(C-22), 20.9(C-23), 19.4(C-24), 17.2(C-25), 16.3(C-26), 14.5(C-27). Its 1H spectrum and 13C spectrum are displayed in Fig. 1E and Fig. 1F, respectively. According to the 1H spectra, δ 7.265 ppm is the solvent peak of CDCl3, and δ 5.37–5.32 (m, 1H) indicates that there is a double-bond H in the compound. Considering the two double C bond signals of δ 140.8(C-1) and 121.5(C-2) in the 13C spectrum, it can be concluded that there is a C = C double bond in this compound. The 1H spectra δ 4.40 (q, J = 7.5 Hz, 1H), 3.49 (ddq, J = 25.7, 10.9, 3.4, 2.3 Hz, 2H), and 3.37 (t, J = 10.9 Hz, 1H) indicate that there are four CH or CH2 signals connected with oxygen in the compound. According to the four C signals connected with oxygen in the C spectrum δ109.3(C-3), 80.9(C-4), 71.8(C-5), and 66.9(C-6), it can be deduced that there are four O atomic signals in the compound. Four characteristic methyl peaks of diosgenin are found in the high field of 13C spectrum, which are δ 19.4(C-24), 17.2(C-25), 16.3(C-26), and 14.5(C-27), respectively. Compared with the 1H and 13C spectra of the compound with diosgenin standard in Fig. 1E and Fig. 1F, it can be concluded that the diosgenin-like crystal product was diosgenin (C27H42O3).
The species identification of the target strain
By comparing the 16S DNA sequence (Supplementary Material 1) with the NCBI database data using phylogenetic analysis method (Accession number: PRJEB32851), the result indicated that the target strain belonged to a sub-branch of the Bacillus licheniformis and it shared a high sequence similarity with Bacillus licheniformis (GI 2,200,464) as Fig. 2 showed. The strain was therefore named B. licheniformis SYt1. It had been preserved in China General Microbiological Culture Collection Center (CGMCC), and the deposit number was 2334.
The TEM photograph of Syt1 is shown in Fig. 3A. It looks like a straight and round-ended rod, with peritrichous flagella indicating motility. There is no apparent capsule observed by TEM. A wrinkled and undulating surface can be clearly observed by the atomic force microscope (AFM) from Fig. 3B. It also can be observed that the shape of the strain actually is a flat rod with ciliated edges, indicating that Syt1 presented powerful adhesion. Its size is about 1.5 ~ 3.0 μm length × 0.5 ~ 0.8 μm width according to the scale of AFM.
Effect of pH on diosgenin yield and pH optimization in batch fermentation
Effect of pH values on the production rate of diosgenin and optimization strategy are illustrated in Fig. 4. From Fig. 4A, it can be seen that the production rate of diosgenin increases with increasing fermentation time for any single pH control at first. Next, there is a maximum production rate appearing at an optimal fermentation time point, and then decreases with the extension of the fermentation time whatever for anyone fixed pH value. When pH increases by 0.5 unit in the range from 5.5 to 8.5, the corresponding maximal production rate of diosgenin is 1.69 ± 0.081 mg L−1 h−1, 1.88 ± 0.074 mg L−1 h−1, 1.80 ± 0.055 mg L−1 h−1, 1.51 ± 0.065 mg L−1 h−1, 1.17 ± 0.088 mg L−1 h−1, 0.73 ± 0.045 mg L−1 h−1, and 0.39 ± 0.033 mg L−1 h−1, respectively; the corresponding time points are at 16 h, 24 h, 32 h, 36 h, 37 h, 52 h, and 56 h, respectively. Moreover, when the fermentation time varies from 60 to 80 h, the production rate of diosgenin rapidly decreases at pH 5.5, 6.0, and 6.5, and closes to 0 at 80 h, but at that moment the production rate of diosgenin still maintains at 0.21 ± 0.043 mg L−1 h−1, 0.42 ± 0.050 mg L−1 h−1, and 0.33 ± 0.036 mg L−1 h−1 at pH7.0, 7.5, and 8.0, respectively. Therefore, a phased pH control is very beneficial to improve production rate of diosgenin.
Effect of pH values on the production rate of diosgenin and optimization strategy. A Effect of pH on production rate of diosgenin; B phased pH optimization control strategy; C schematic diagram of maximum production rate of diosgenin using phased pH control strategy; D verification of maximum yield using phased pH control strategy
When the phased pH control strategy as showed in Fig. 4B is used, the maximum theoretical yield of diosgenin should be the shaded area shown in Fig. 4C. The practice results of the phased pH control strategy indicated that the diosgenin yield was 85 ± 8.6 mg L−1, significantly higher than that of any single-pH control (yield in order from low pH to high pH: 38.9 ± 6.8 mg L−1; 43.7 ± 7.1 mg L−1; 50.4 ± 4.8 mg L−1; 54.4 ± 4.9 mg L−1; 42.1 ± 6.3 mg L−1; 40.9 ± 5.9 mg L−1; 28.1 ± 4.5 mg L−1) as shown in Fig. 4D. Thence, the phased pH control strategy is actually beneficial to improve the batch fermentation yield of diosgenin of SYt1.
Discussion
In this work, an endogenous Bacillus licheniformis SYt1 was firstly isolated from DZW, which was proved to produce diosgenin. As one of the sterol family, diosgenin was often synthesized by eukaryotes for critical cellular functions including maintaining membrane fluidity, phagocytosis, stress tolerance, and cell signaling (Riobo 2012; Wei et al. 2016), but not typically produced by bacteria, because bacteria still lacked homologs of the eukaryotic proteins required for the modifications such as demethylation and saturation in metabolic pathway. However, a few bacterial species such as γ-proteobacteria (Banta et al. 2015) and δ-proteobacteria (Bode et al. 2003) had been reported to produce cholesterol, a kind of sterol with a similar structure to diosgenin. Bacterial sterol synthesis pathways are still unknown (Wei et al. 2016). Given the sporadic and sparse distribution of sterol synthesis in the bacterial domain, it has been suggested that bacteria most likely acquired this biosynthetic pathway through horizontal gene transfer from eukaryotes (Bode et al. 2003; Summons et al. 2006; Wei et al. 2016). This reasoning has not been confirmed. B. licheniformis SYt1 is one endogenous bacterium of DZW, and horizontal gene transfer might highly probably happen between them. However, very few information is available for discussion. If the horizontal gene transfer was true, the strain should produce saponins in its metabolic process. Unfortunately, saponins have not been determined by us in the process, which suggested that another compound similar to diosgenin in structure might be formed in the strains. A possible biosynthesis pathway of diosgenin in plant is illustrated in Fig. 5 according to the previous reports (Ciura et al. 2017; Zolfaghari et al. 2020). In this way, acetyl-CoA is converted to isopentenyl pyrophosphate (IPP) through MVA pathway, and the latter is transformed to cholesterol through subsequent 13 possible steps. Cholesterol is subsequently metabolized to be diosgenin undergoing 7-step biocatalytic reactions. All organisms must be able to produce both IPP (Thibodeaux and Liu 2017). Therefore, cholesterol probably is one critical precursor of diosgenin.
A verification experiment was performed by us through adding cholesterol as the sole carbon source in medium. The obtained results are displayed in Fig. 6. Lane 1 indicates that no conversion from added cholesterol (0.01 g/L) as sole carbon source to diosgenin happened when no living strain SYt1 was inoculated in medium. Lane 2 shows that some added cholesterol had been converted to diosgenin by inoculated strain SYt1 in medium when 0.2 g/L cholesterol was added as sole carbon source. Lane 5 shows that all cholesterol in Lane 2 had been almost converted to diosgenin by the presented strain SYt1. Therefore, the results suggested that cholesterol may be one precursor of diosgenin. Because it was found that diosgenin production rate was directly proportional to cell biomass of SYt1, the potential precursors were presumed to exist in the cell wall of SYt1.
Conversion evidence from cholesterol to diosgenin using thin-layer chromatography. Lane 1: control (no strain SYt1 inoculation, 0.01 g/L cholesterol addition); lane 2: part bioconversion of cholesterol to diosgenin by strain SYt1 (0.2 g/L cholesterol addition); lane 3: cholesterol standard (0.2 g/L); lane 4: diosgenin standard (0.2 g/L); lane 5: almost complete bioconversion of cholesterol to diosgenin by strain SYt1 (0.2 g/L cholesterol addition); lane 6: cholesterol standard (0.2 g/L); lane 7: diosgenin standard (0.2 g/L)
The biosynthesis of diosgenin was a multi-step biocatalytic reaction process, in which it required the step-by-step participation of multiple enzymes (Ciura et al. 2017; Zolfaghari et al. 2020), and the optimal pH might vary from step to step for diogenin biosynthesis. Therefore, an optimized pH adjustment seems to be necessary to improve the yield of diosgenin. The practical results in Fig. 4 indicated that the phased pH optimization control strategy was suitable for the multi-step biocatalytic reaction process of precursors or diosgenin, while some parallel reactions may be suppressed. The dynamic pH control strategy has achieved excellent results in the batch fermentation tests of other microorganisms (Feng et al. 2014; Wu et al. 2017; Yue et al. 2021).
Admittedly, this is a complicated multi-step process. To expose this mechanism, the corresponding enzymes are needed to be further purified and simulated these biocatalytic reactions, which is a very burdensome and difficult work. However, it is a very interesting and worth exploring topic in metabolomics and genomics in the future.
Most papers about the microbial production methods of diosgenin relied on microorganisms to convert the saponins in DZW to diosgenin in vivo instead of acid hydrolysis process of plant in vitro (Chen et al. 2018; Cheng et al. 2015; Liu et al. 2010; Zhu et al. 2010). The proposed method is different from previous reports because it does not require DZW to produce diosgenin. In short, this study demonstrates that endogenous B. licheniformis SYt1 isolated from DZW can produce diosgenin in fermentation processing. pH plays an important role to improve the yield of diosgenin in the process under aerobic culture conditions. A phased pH optimization control strategy from 5.5 to 7.5 can get maximal yield 85 ± 8.6 mg L−1 diosgenin, which is higher than that of any single pH control. This is a new way to produce diosgenin through microorganism fermentation without DZW as substrate, which may replace large amounts of plant extracts to produce diosgenin in the future.
Data availability
All data generated or analyzed during this study are included in this published article.
References
Bai Y, Zhang L, Jin W, Wei M, Zhou P, Zheng G, Niu L, Nie L, Zhang Y, Wang H, Yu L (2015) In situ high-valued utilization and transformation of sugars from Dioscorea zingiberensis C.H. Wright for clean production of diosgenin. Bioresour Technol 196:642–647. https://doi.org/10.1016/j.biortech.2015.08.010
Banta AB, Wei JH, Welander PV (2015) A distinct pathway for tetrahymanol synthesis in bacteria. Proc Natl Acad Sci U S A 112(44):13478–13483. https://doi.org/10.1073/pnas.1511482112
Bode HB, Zeggel B, Silakowski B, Wenzel SC, Reichenbach H, Müller R (2003) Steroid biosynthesis in prokaryotes: identification of myxobacterial steroids and cloning of the first bacterial 2,3(S)-oxidosqualene cyclase from the myxobacterium Stigmatella aurantiaca. Mol Microbiol 47(2):471–481. https://doi.org/10.1046/j.1365-2958.2003.03309.x
Cavagna M, Dell’Anna R, Monti F, Rossi F, Torriani S (2010) Use of ATR-FTIR microspectroscopy to monitor autolysis of Saccharomyces cerevisiae cells in a base wine. J Agric Food Chem 58(1):39–45. https://doi.org/10.1021/jf902369s
Chen Y, Dong Y, Chi Y, He Q, Wu H, Ren Y (2018) Eco-friendly microbial production of diosgenin from saponins in Dioscorea zingiberensis tubers in the presence of Aspergillus awamori. Steroids 136:40–46. https://doi.org/10.1016/j.steroids.2018.05.005
Chen Y, Tang Y-M, Yu S-L, Han Y-W, Kou J-P, Liu B-L, Yu B-Y (2015) Advances in the pharmacological activities and mechanisms of diosgenin. Chin J Nat Medicines 13(8):578–587. https://doi.org/10.1016/S1875-5364(15)30053-4
Cheng Y, Dong C, Huang C, Zhu Y (2015) Enhanced production of diosgenin from Dioscorea zingiberensis in mixed culture solid state fermentation with Trichoderma reesei and Aspergillus fumigatus. Biotechnol Biotechnol Equip 29(4):773–778. https://doi.org/10.1080/13102818.2015.1032352
Ciura J, Szeliga M, Grzesik M, Tyrka M (2017) Next-generation sequencing of representational difference analysis products for identification of genes involved in diosgenin biosynthesis in fenugreek (Trigonella foenum-graecum). Planta 245(5):977–991. https://doi.org/10.1007/s00425-017-2657-0
Davies D (1990) Chirality, drug metabolism and action. Academic Press, Salt Lake City, pp 45–51
Dawson RF (1991) Diosgenin production in North America-a brief history. HortTechnology 1(1):22–27. https://doi.org/10.21273/horttech.1.1.22
Duan J, Dong X, Shen Y, Gao B, Zhang Z, Gao T, Wang M (2018) Simultaneous determination of enantiomers of carfentrazone-ethyl and its metabolite in eight matrices using high-performance liquid chromatography with tandem mass spectrometry. J Sep Sci 41(19):3697–3705. https://doi.org/10.1002/jssc.201701349
Eibler D, Vetter W (2017) Enantioseparation and optical rotation of flavor-relevant 4-alkyl-branched fatty acids. J Chromatogr A 1505:87–95. https://doi.org/10.1016/j.chroma.2017.05.011
Feng S, Yang H, Zhan X, Wang W (2014) Novel integration strategy for enhancing chalcopyrite bioleaching by Acidithiobacillus sp. in a 7-L fermenter. Bioresour Technol 161:371–378. https://doi.org/10.1016/j.biortech.2014.03.027
Fernandes P, Cruz A, Angelova B, Pinheiro HM, Cabral JMS (2003) Microbial conversion of steroid compounds: recent developments. Enzyme Microb Technol 32(6):688–705. https://doi.org/10.1016/S0141-0229(03)00029-2
Gong N, Wang Y, Zhang B, Yang D, Du G, Lu Y (2019) Screening, preparation and characterization of diosgenin versatile solvates. Steroids 143:18–24. https://doi.org/10.1016/j.steroids.2018.11.016
Kos G, Lohninger H, Krska R (2003) Development of a method for the determination of fusarium fungi on corn using mid-infrared spectroscopy with attenuated total reflection and chemometrics. Anal Chem 75(5):1211–1217. https://doi.org/10.1021/ac0260903
Kumar S, Stecher G, Tamura K (2016) MEGA7: molecular evolutionary genetics analysis Version 7.0 for Bigger Datasets. Mol Biol Evol 33(7):1870–1874. https://doi.org/10.1093/molbev/msw054
Lepage C, Liagre B, Cookmoreau J, Pinon A, Beneytout JL (2010) Cyclooxygenase-2 and 5-lipoxygenase pathways in diosgenin-induced apoptosis in HT-29 and HCT-116 colon cancer cells. Int J Oncol 36(5):1183–1191. https://doi.org/10.3892/ijo_00000601
Li P, Mou Y, Lu S, Sun W, Lou J, Yin C, Zhou L (2012) Quantitative determination of diosgenin in Dioscorea zingiberensis cell cultures by microplate- spectrophotometry and high-performance liquid chromatography. Afr J Pharm Pharmacol 6(15):1186–1193. https://doi.org/10.5897/AJPP11.440
Liu L, Dong Y-S, Qi S-S, Wang H, Xiu Z-L (2010) Biotransformation of steriodal saponins in Dioscorea zingiberensis C. H. Wright to diosgenin by Trichoderma harzianum. Appl Microbiol Biotechnol 85(4):933–940. https://doi.org/10.1007/s00253-009-2098-1
Macêdo RO, Barbosa-Filho JM, da Costa EM, de Souza AG (1999) Thermal behaviour of some terpenoids. J Therm Anal Calorim 56(3):1353–1357. https://doi.org/10.1023/a:1010110624198
Mamay, Wahyuningrum D., Hertadi R (2015) Isolation and characterization of levan from moderate halophilic bacteria Bacillus licheniformis BK AG21. Procedia Chemistry 16:292–298. https://doi.org/10.1016/j.proche.2015.12.055
Pan C, Zhao Y, Liu G, Dou G, Ru Z, Zhu K (2014) Development and demonstration of a cleaner process to produce diosgenin from Dioscorea zingiberensis based on physical separation. J Clean Prod 76:161–166. https://doi.org/10.1016/j.jclepro.2013.12.074
Pidiyar VJ, Jangid K, Dayananda KM, Kaznowski A, Gonzalez JM, Patole MS, Shouche YS (2003) Phylogenetic affiliation of Aeromonas culicicola MTCC 3249T based on gyrB gene sequence and PCR-amplicon sequence analysis of cytolytic enterotoxin gene. Syst Appl Microbiol 26(2):197–202. https://doi.org/10.1078/072320203322346047
Riobo NA (2012) Cholesterol and its derivatives in Sonic Hedgehog signaling and cancer. Curr Opin Pharmacol 12(6):736–741. https://doi.org/10.1016/j.coph.2012.07.002
Summons RE, Bradley AS, Jahnke LL, Waldbauer JR (2006) Steroids, triterpenoids and molecular oxygen. Philos Trans R Soc Lond B Biol Sci 361(1470):951–968. https://doi.org/10.1098/rstb.2006.1837
Thibodeaux CJ, Liu H-w (2017) The type II isopentenyl diphosphate:dimethylallyl diphosphate isomerase (IDI-2): a model for acid/base chemistry in flavoenzyme catalysis. Arch Biochem Biophys 632:47–58. https://doi.org/10.1016/j.abb.2017.05.017
Wang P, Ma C, Chen S, Zhu S, Lou Z, Wang H (2014) Conversion of steroid saponins into diosgenin by catalytic hydrolysis using acid-functionalized ionic liquid under microwave irradiation. J Clean Prod 79:265–270. https://doi.org/10.1016/j.jclepro.2014.05.041
Wei JH, Yin X, Welander PV (2016) Sterol synthesis in diverse bacteria. Front Microbiol 7(990):1–19. https://doi.org/10.3389/fmicb.2016.00990
Wei M, Bai Y, Ao M, Jin W, Yu P, Zhu M, Yu L (2013) Novel method utilizing microbial treatment for cleaner production of diosgenin from Dioscorea zingiberensis C.H. Wright (DZW). Bioresour Technol 146:549–555. https://doi.org/10.1016/j.biortech.2013.07.090
Wu Y, Wang C, Zheng M, Zuo J, Wu J, Wang K, Yang B (2017) Effect of pH on ethanol-type acidogenic fermentation of fruit and vegetable waste. Waste Manage (oxford) 60:158–163. https://doi.org/10.1016/j.wasman.2016.09.033
Yang H, Yin H, Shen Y, Xia G, Zhang B, Wu X, Cai B, Tam JP (2016) A more ecological and efficient approach for producing diosgenin from Dioscorea zingiberensis tubers via pressurized biphase acid hydrolysis. J Clean Prod 131:10–19. https://doi.org/10.1016/j.jclepro.2016.05.030
Yue L, Chuan S, Yuanyuan W, Han D, Li K, Jinyuan M, Kaijun W (2021) Effect of pH dynamic control on ethanol-lactic type fermentation (ELTF) performance of glucose. Environ Technol 1–13. https://doi.org/10.1080/09593330.2021.1942560
Zhang L, Zuo B, Wu P, Wang Y, Gao W (2012) Ultrasound effects on the acetylation of dioscorea starch isolated from Dioscorea zingiberensis C.H. Wright. Chem Eng Process 54(4):29–36. https://doi.org/10.1016/j.cep.2012.01.005
Zhang Y, Tang L, An X, Fu E, Ma C (2009) Modification of cellulase and its application to extraction of diosgenin from Dioscorea zingiberensis C.H. Wright. Biochem Eng J 47(1):80–86. https://doi.org/10.1016/j.bej.2009.07.006
Zhang YQ, Liang JH, Fu EH, Li BX (2007) Effect of modified enzymatic catalysis on the extraction of diosgenin from Dioscorea zingiberensis C H Wright. Chem Eng Technol 30(11):1488–1494. https://doi.org/10.1002/ceat.200700234
Zhu Y-L, Huang W, Ni J-R, Liu W, Li H (2010) Production of diosgenin from Dioscorea zingiberensis tubers through enzymatic saccharification and microbial transformation. Appl Microbiol Biotechnol 85(5):1409–1416. https://doi.org/10.1007/s00253-009-2200-8
Zolfaghari F, Rashidi-Monfared S, Moieni A, Abedini D, Ebrahimi A (2020) Improving diosgenin production and its biosynthesis in Trigonella foenum-graecum L. hairy root cultures. Industrial Crops and Products 145:112075. https://doi.org/10.1016/j.indcrop.2019.112075
Acknowledgements
We thank the colleagues in research platform of College of Life Sciences provided experimental convenience in the work.
Funding
The work was supported by the Shaanxi Province Strategic Emerging Industry Major Product (Group) Project (No. 2015KTCQ03-05) and the Shaanxi Province Key R&D Program (2021SF-387).
Author information
Authors and Affiliations
Contributions
C. L. W. is equal to the first author. Z. Q. H. and B. F. Q. conceived the project, and designed the experiments. Z. Q. H., C. L. W., and L. F. Z. analyzed the results and wrote the manuscript. L. T. P., S. Y. H., M. J., Y. S. X., and R. C. constructed and executed all the experiments. Z. H. L. polished the whole paper. All authors read and approved the manuscript.
Corresponding author
Ethics declarations
Ethical approval
This article does not contain any studies with human participants performed by any of the authors.
Conflict of interest
The authors declare no competing interests.
Additional information
Publisher's note
Springer Nature remains neutral with regard to jurisdictional claims in published maps and institutional affiliations.
Zhongqiu Hu is the first author.
Supplementary Information
Below is the link to the electronic supplementary material.
Rights and permissions
About this article
Cite this article
Hu, Z., Wang, C., Pan, L. et al. Identification and a phased pH control strategy of diosgenin bio-synthesized by an endogenous Bacillus licheniformis Syt1 derived from Dioscorea zingiberensis C. H. Wright. Appl Microbiol Biotechnol 105, 9333–9342 (2021). https://doi.org/10.1007/s00253-021-11679-z
Received:
Revised:
Accepted:
Published:
Issue Date:
DOI: https://doi.org/10.1007/s00253-021-11679-z